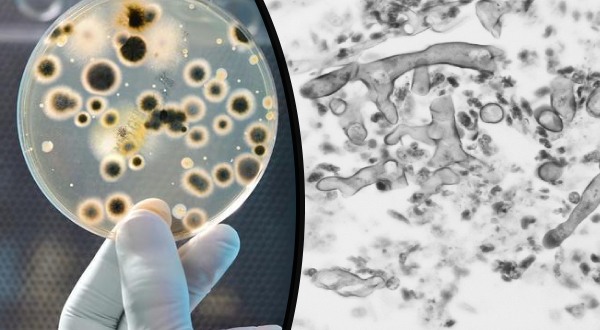

“চিকিৎসকদের সঙ্গে কথা বলে আমরা এটুকু বুঝতে পারছি যে কোভিড আক্রান্ত রোগীদের অক্সিজেন স্যাচুরেশন কমে গেলে বাড়িতে থেকে চিকিৎসা সম্পূর্ণ ফলপ্রসূ হবে না। হাসপাতালে ভর্তি করা ভীষণভাবে প্রয়োজন। কিন্তু যখন হাসপাতালেও প্রয়োজনীয় শয্যা পাওয়া যাচ্ছে না, তখন যতটুকু পাশে থাকতে পারি আমরা, সেই চেষ্টাই চালিয়ে যাচ্ছি।” বলছিলেন মণিদীপা শীল। সম্প্রতি কলকাতা শহরতলির অক্সিজেনের চাহিদা পূরণ করতে এগিয়ে এসেছেন কয়েকজন তরুণ-তরুণী। অক্সিজেন কনসেন্ট্রেটর যন্ত্র নিয়ে পৌঁছে যাচ্ছেন আক্রান্তদের বাড়িতে। তাঁদেরই একজন মণিদীপা।
উদ্যোগের অপর একজন সঙ্গী সৌত্রিক চক্রবর্তী জানালেন, “আমার বাড়ির অক্সিজেন কন্সেন্ট্রেটর যন্ত্রটি কেনা হয়েছিল ২০১২ সালে। ঠাকুরমা সিওপিডি রোগী ছিলেন। তাঁর জন্য সর্বক্ষণ অক্সিজেন সরবরাহের দরকার হতো। ২০১৫ সালে ঠাকুরমা মারা যান। তারপর থেকে পড়ে থাকতে থাকতে যন্ত্রটি খারাপ হয়ে যায়। করোনা অতিমারীর দ্বিতীয় তরঙ্গে যখন চারিদিকে অক্সিজেনের আকাল, তখন সেটিকে সারানোর সিদ্ধান্ত নিই। সামাজিক মাধ্যমে ক্রাউড ফান্ডিং-এর আবেদন জানাই। আর তাতে যন্ত্রটি সারানোর জন্য প্রয়োজনীয় অর্থের কিছুটা বেশিই উঠে এসেছে।” সোমবার যন্ত্রটি মেরামতির পর হাতে পান সৌত্রিক। এরপর দুদিনের প্রস্তুতি নিয়ে বুধবার কাজ শুরু করেছেন সৌত্রিক ও তাঁর বন্ধুরা। ডানলপ থেকে খড়দা পর্যন্ত যে কোনো জায়গার মানুষের প্রয়োজনে পৌঁছে যাচ্ছেন প্রয়োজনীয় সতর্কতা নিয়েই। অক্সিজেন দেওয়ার জন্য পরে নিচ্ছেন পিপিই কিট। নিজেদের উদ্যোগেই নিজেরা হয়ে উঠেছেন এক একজন কোভিড-যোদ্ধা।


একদিকে যেমন একটিমাত্র অক্সিজেন কনসেন্ট্রেটর যন্ত্র নিয়ে লড়াই চালিয়ে যাচ্ছেন ৫ বন্ধু, অন্যদিকে আবার তরুণ-তরুণীদের আরও একটি দল জোগাড় করে ফেলেছেন ২০টি অক্সিজেন সিলিন্ডার। এক্ষেত্রেও সামাজিক মাধ্যমের সূত্রেই অর্থ সংগ্রহ করেছেন বলে জানালেন অরবিন্দ মূলে। জানালেন, “আপাতত আমরা অক্সিজেন সিলিন্ডার জোগাড় করতে পেরেছি। তবে তা রোগীদের কাছে পৌঁছে দেওয়ার জন্য আরও কিছুটা প্রস্তুতি দরকার। সিলিন্ডারের সঙ্গে ভালব ও অন্যান্য আনুষাঙ্গিক যন্ত্র কেনা বাকি। তাছাড়া সিলিন্ডারের পাশাপাশি অক্সিজেন মাস্ক এবং টিউবেরও কালোবাজারি চলছে। সেগুলোও আমরাই সংগ্রহ করে পৌঁছে দেওয়ার ব্যবস্থা করব। সব মিলিয়ে কাজ শুরু করতে আরও দিন দুয়েক লাগবে।” কিছুদিন আগেই এই তরুণ-তরুণীরা রাজ্যের নানা প্রান্তে হাসপাতালের শয্যা, অক্সিজেন ও ওষুধের জোগান সম্পর্কিত তথ্য পৌঁছে দিতে তৈরি করেছিলেন একটি ওয়েবসাইট। ‘সমন্বয়িং’ নামের সেই ওয়েবসাইট থেকেই সমগ্র বিষয়টি পরিচালনা করা হবে। অরবিন্দ জানালেন, “কলকাতা শহরের পাশাপাশি বারাসাতে অক্সিজেনের সংকট অত্যন্ত বেশি। এছাড়া আসানসোল, হাওড়া এইসমস্ত জায়গায় সিলিন্ডার পৌঁছে দেওয়ার ব্যবস্থা করছি আমরা। আসলে সব জায়গাতেই তো প্রয়োজন। আমাদের যতটুকু সামর্থ্য, সেই অনুযায়ীই চেষ্টা করে যাবো।”
আরও পড়ুন
ঘাটতি মেটাতে অক্সিজেন কনসেন্ট্রেটর আনাচ্ছে দিল্লির হাসপাতাল

আরও পড়ুন
কোভিড-যুদ্ধে হায়দ্রাবাদের সাইক্লিস্টরা; দু’চাকায় ভর করেই পৌঁছে যাচ্ছে অক্সিজেন, ওষুধ
কোভিড আক্রান্ত রোগীদের প্রাথমিক উপসর্গ অক্সিজেন স্যাচুরেশন কমে যাওয়া। তাই অক্সিজেনের চাহিদাই সবচেয়ে বেশি। জোগান কম হওয়ার কারণেই বাড়ছে কালোবাজারিও। শহর কলকাতায় কোথাও কোথাও ৬০ হাজার থেকে ৮০ হাজার টাকায় বিক্রি হচ্ছে এক একটি সিলিন্ডার। এই সময়েই পরিস্থিতি মোকাবিলায় এগিয়ে এলেন তরুণ তরুণীরা। নিজেদের মতো ব্যবস্থা করার পাশাপাশি তাঁরাই আবার বিভিন্ন হাসপাতালের সঙ্গে যোগাযোগ বজায় রাখছেন। কারণ রোগীদের উপযুক্ত চিকিৎসা দিতে হাসপাতালের পরিকাঠামো বাড়িতে দেওয়া সম্ভব নয়। মণিদীপার কথায়, “ইতিমধ্যে বেশ কিছু হাসপাতালে শয্যা সংখ্যা বাড়ানো হচ্ছে। হয়তো কিছুদিনের মধ্যে পরিস্থিতি কিছুটা নিয়ন্ত্রণে আসবে। হাসপাতালের পরিকাঠামো দিতে আমরা পারব না। কিন্তু বিনা চিকিৎসায় মানুষের মৃত্যু হচ্ছে, এই দৃশ্যটাও বদলাতে হবে আমাদেরই।” দেশের প্রতিটা যুদ্ধকালীন পরিস্থিতিতে এভাবেই বারবার ইতিহাস তৈরি করেছেন তরুণ-তরুণীরা। কোভিড যুদ্ধেও এভাবেই সামনে থেকে দায়িত্ব পালন করে যাচ্ছেন তাঁরা।
আরও পড়ুন
নিজস্ব সঞ্চয় থেকেই ১০০ অক্সিজেন কনসেন্ট্রেটর ক্রয় ৯ বছরের পরিবেশকর্মীর
Powered by Froala Editor